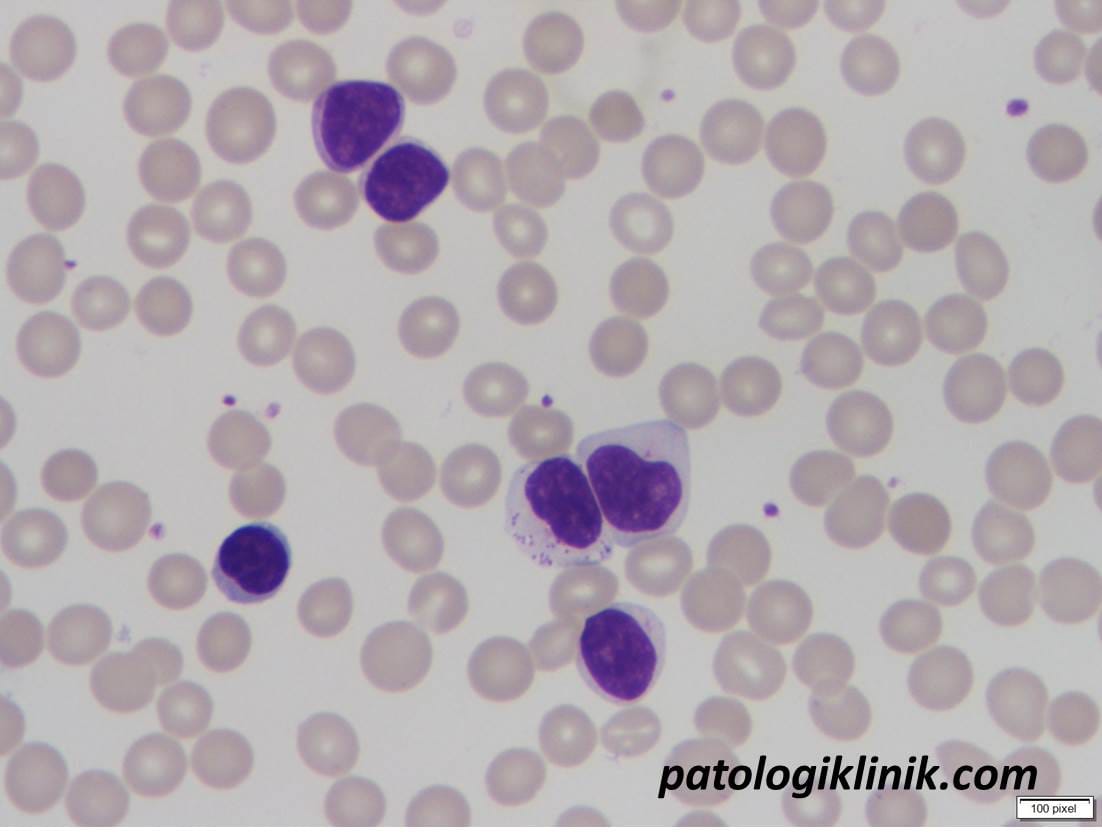
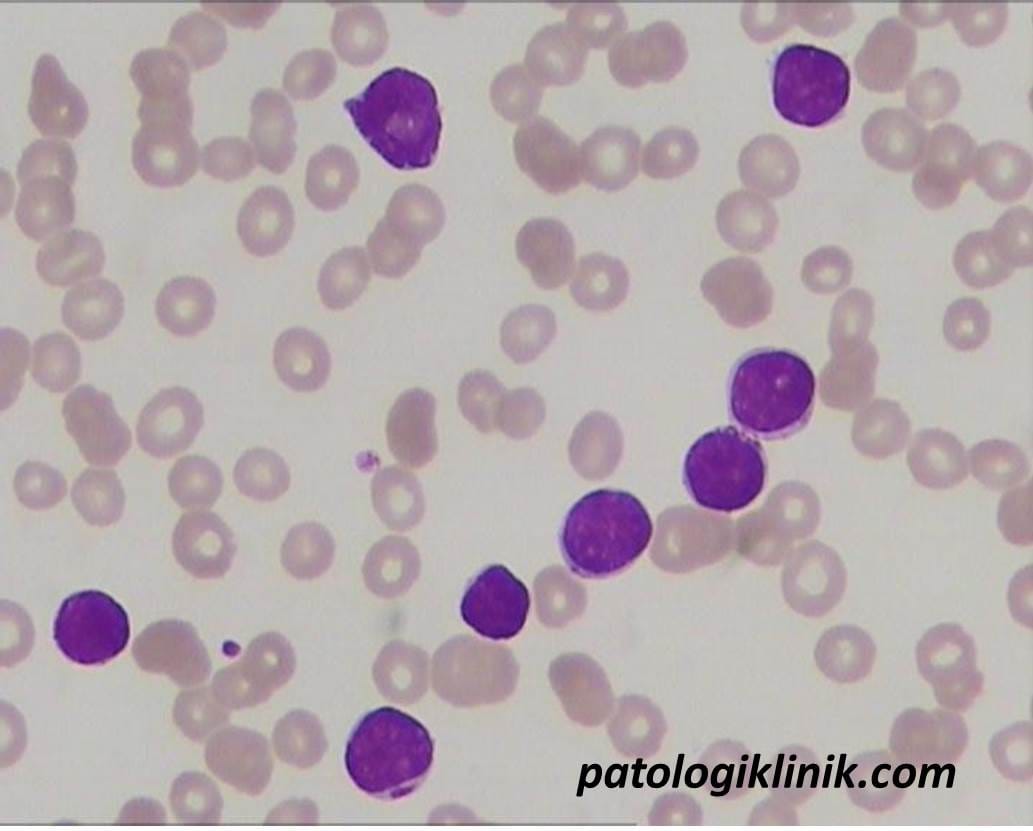
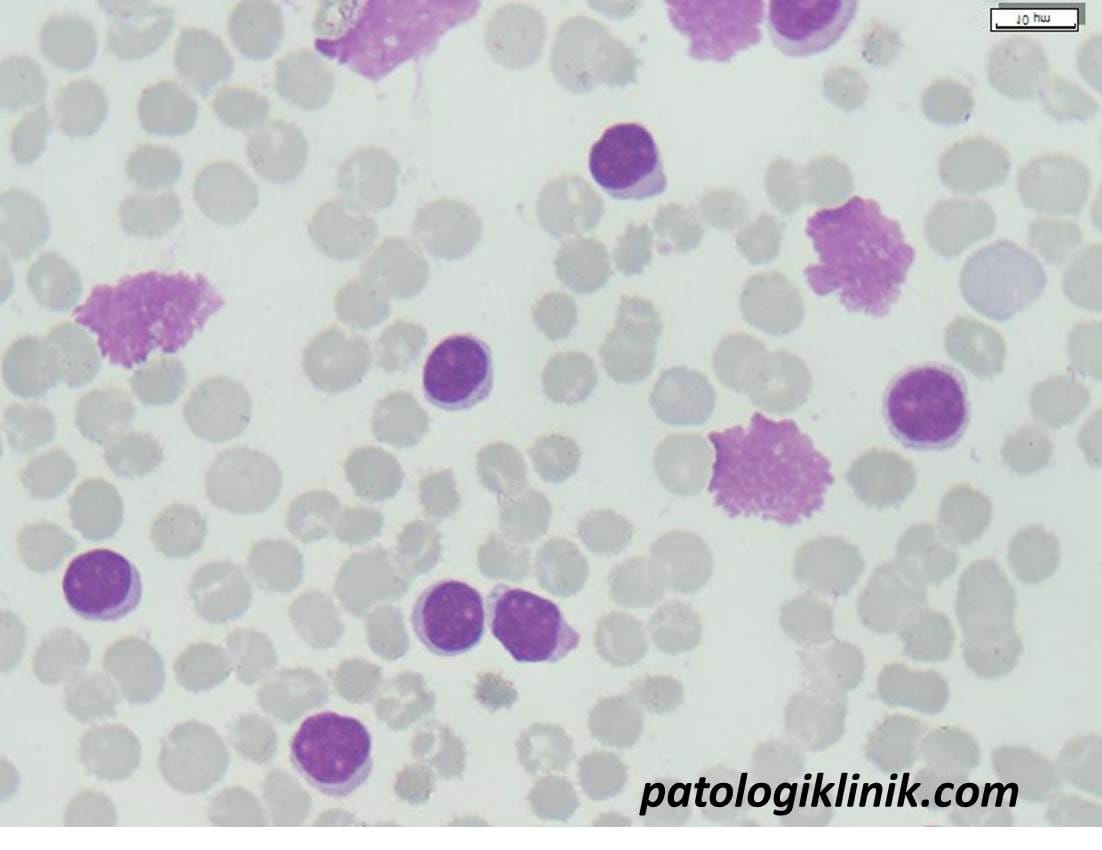

Chronic Lymphocytic Leukemia/Prolymphocytic Leukemia (CLL/PLL)
Chronic Lymphocytic Leukemia/Prolymphocytic Leukemia (CLL/PLL)
- Limfositosis >5×109/L
- 11-54% di antaranya adalah prolimfosit

Limfosit dan prolimfosit pada darah tepi pasien CLL/PLL


Limfosit dan prolimfosit pada sumsum tulang pasien CLL/PLL
